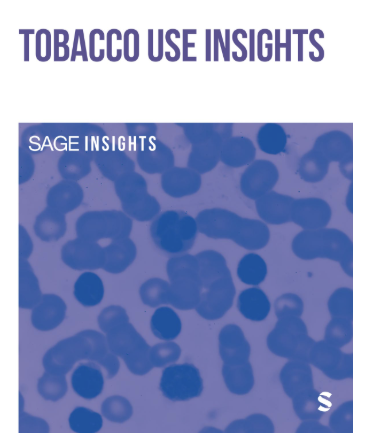

Publications and Research
We deliver rigorous, independent research, including MRC-branded reports and external publications produced by our team of experts, which inform decision-making and contribute meaningfully to policy and market debates relevant to our clients. Explore our latest insights below..
Measuring Financial Innovation and its Impact
Author: Victor Ekpu
Online Peer-to-Peer Lending to Finance Business Growth
Co-authors: Victor Ekpu, Professor Mike Wright, Neha Prashar and Anastasia Ri
Social and Equality Impacts of Brexit
Author: Eve Hepburn
Immigration Policy: The Countdown to Brexit
Author: Eve Hepburn
The Design Economy 2018: The State of Design in the UK
Co-researchers: Karen Bonner, Victor Ekpu, Professor Mark Hart, Laura Heery, Neha Prashar, Professor Stephen Roper
Business Lending and Bank Profitability in the UK
Co-authors: Victor Ekpu & Alberto Paloni
Determinants of Bank Involvement with SMEs
Author: Victor Ekpu
Modelling Monetary Policy and Money Market Rates
Co-authors: Chioma Nwafor and Victor Ekpu
Economic Impact of Smoking and of Reducing Smoking Prevalence
Co-authors: Victor Ekpu & Abraham Brown
Consolidated Supervision of Banks and Financial Conglomerates
Co-authors: Victor Ekpu and Chioma Nwafor
Financial Stability: The Role of Regulation and Supervision
Author: Victor Ekpu
Get in Touch
We would love to hear from you.
Reach out to us for more information about our work or to talk to us about a project